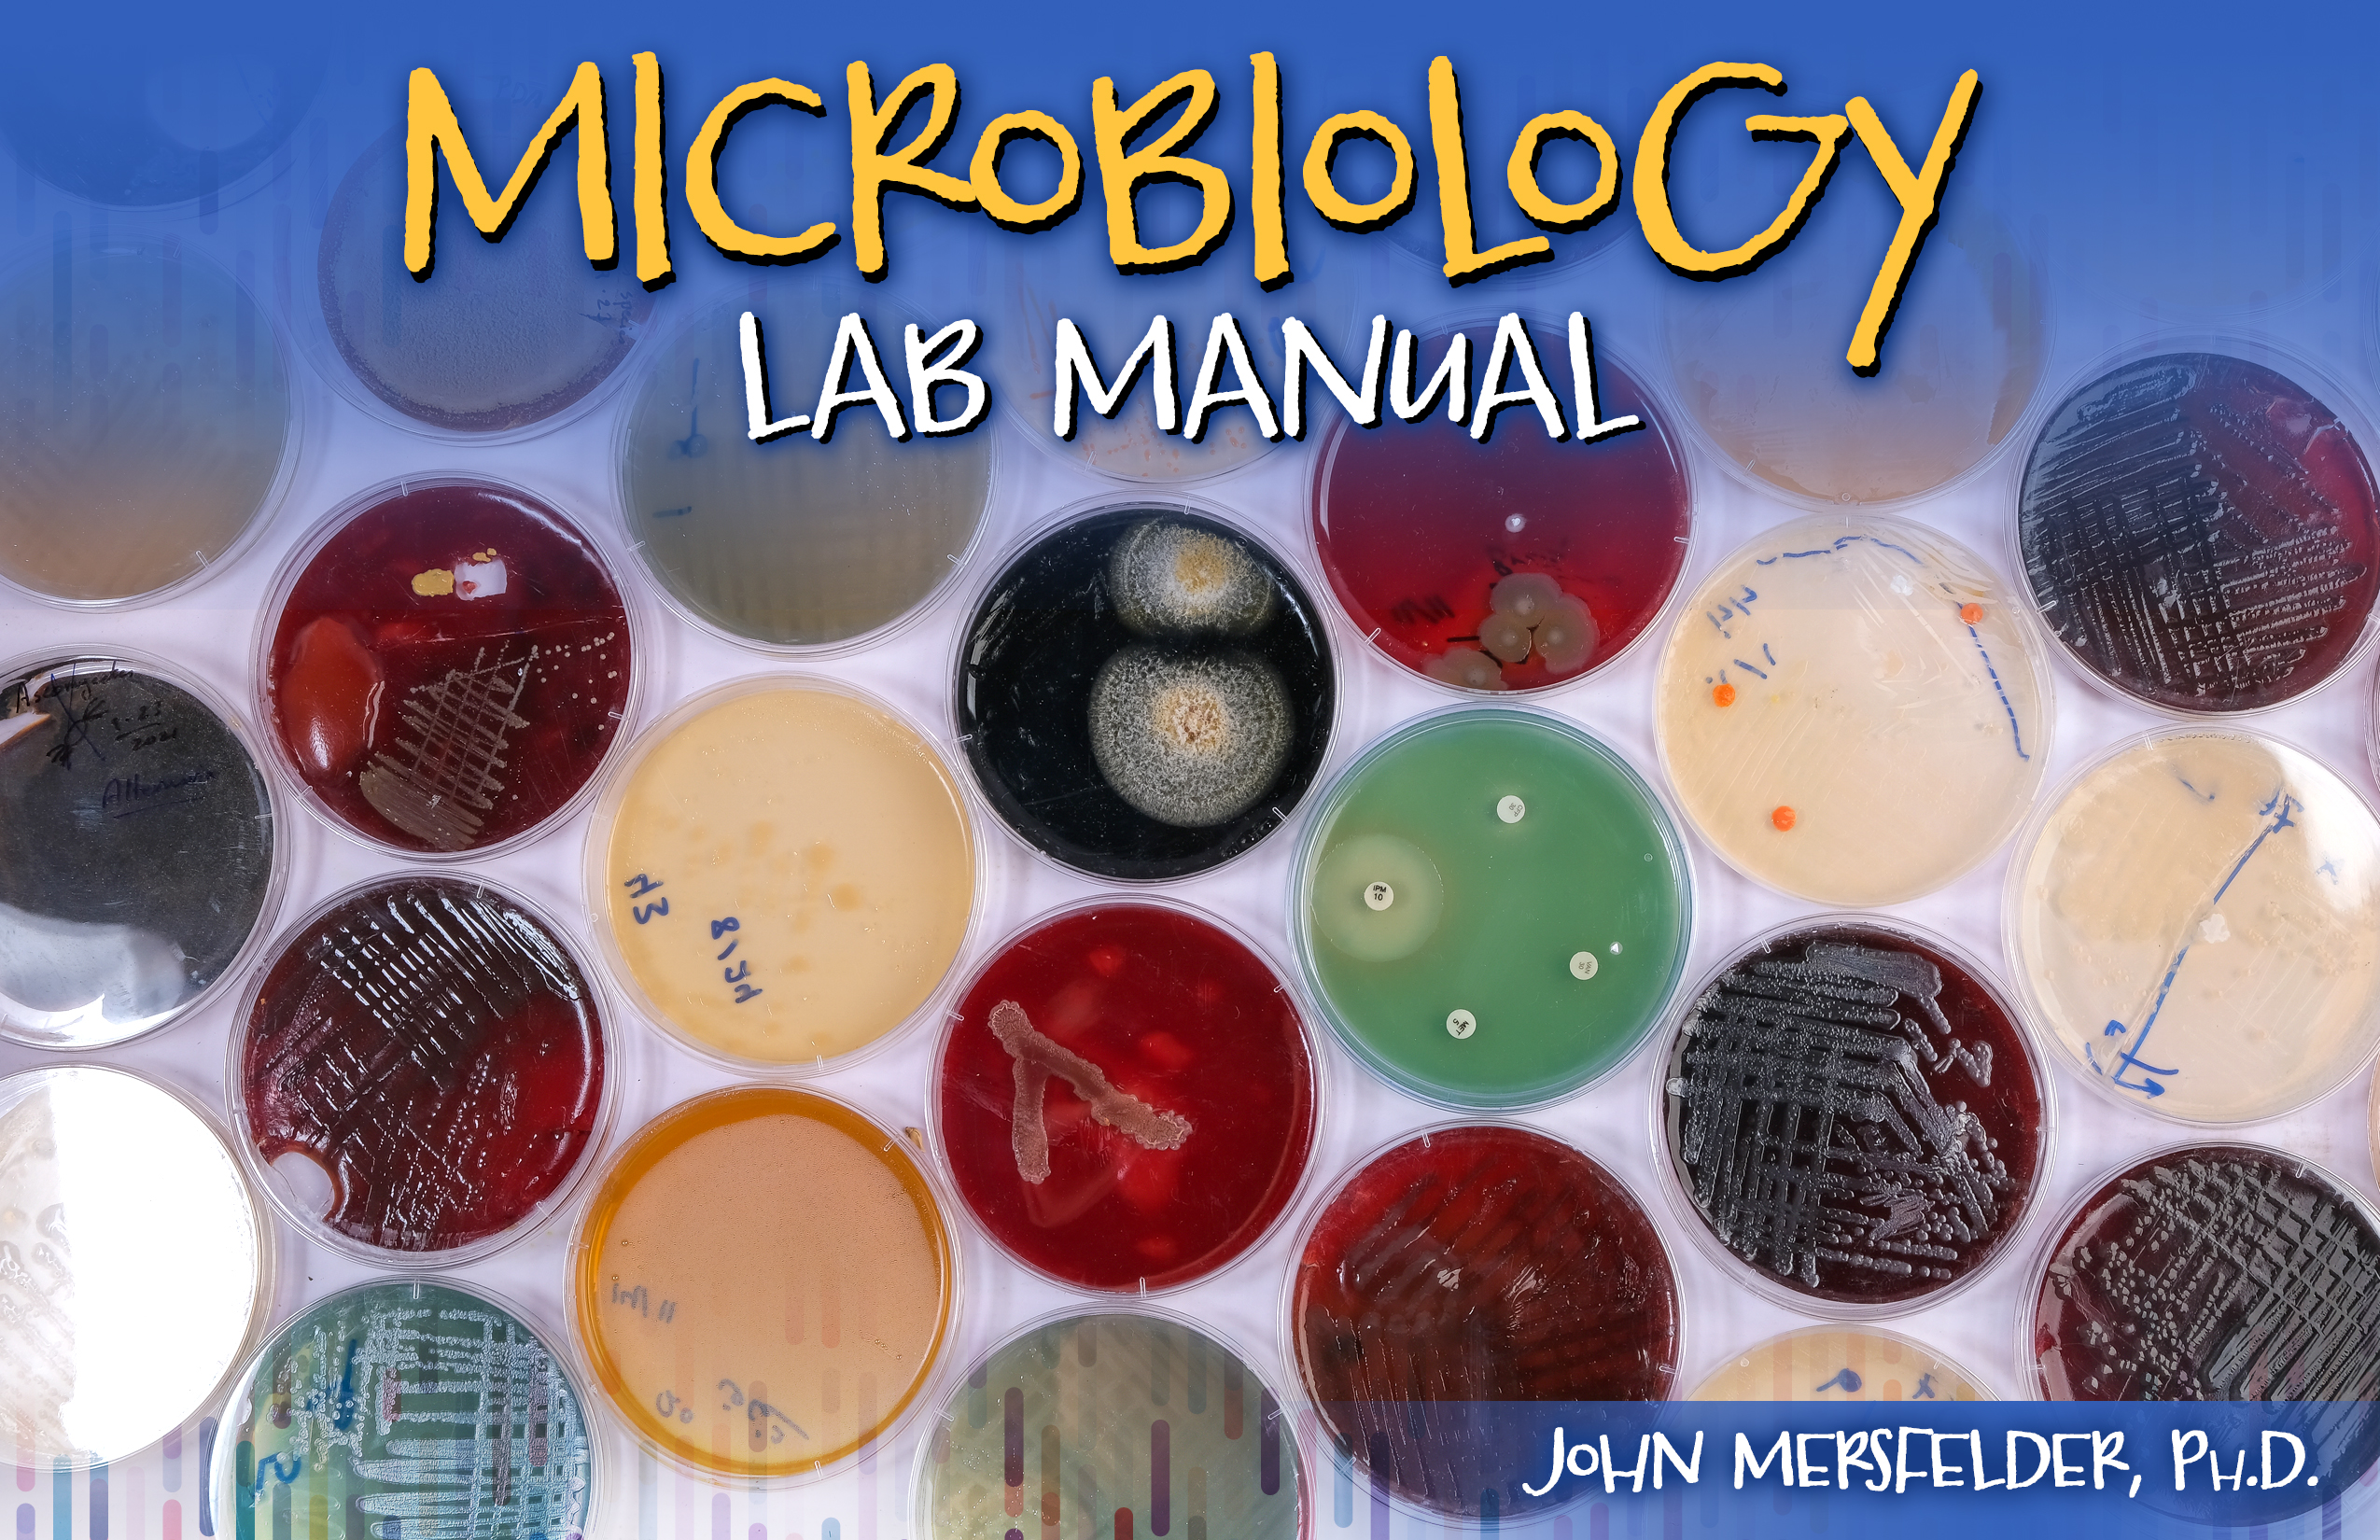
Microbiology Lab Manual

Essential Biology: An Applied Approach is a textbook intended for introductory college biology courses. It uses a society-based approach to guide readers to appreciate biology as it applies to current and historic cultural issues. Essential Biology serves the traditional undergraduate biology curriculum, with a sequence and depth of content valuable for the introductory student. Its unique story- and society-based approach brings forth collaborative discussion and improves student motivation to read and study further into the material.…

After two decades of teaching the two-semester sequence of general biology courses, requiring students to purchase a hefty textbook at a high cost that contained far more chapters than one could ever realistically cover in a typical academic year, the concept of this textbook was born.
This text not only removes materials not covered in most general biology classes (which are covered in courses that follow) but it also condenses the material that is most often taught into a more manageable and usable form. Additionally, this text is written to focus on how the subject of biology fits…

Explorations in General Biology Laboratory is designed for a two semester General Biology course to give students laboratory experiences that will enrich their knowledge and supplement the course. Each laboratory exercise contains a list of objectives, introduction, and procedure, followed by a laboratory report sheet. The order in which the exercises are done may vary with the design of the course.

Introductory Animal Science: The Biology of Domestic Animals delivers the foundation for all future Animal Science courses. Topics including genetics, reproduction, and nutrition provide basic understanding of the major Animal Science disciplines. Additional topics of anatomy, animal health, and animal/environment interactions outline the essentials of animal care. Laboratory exercises, homework assignments, and chapter review questions supplement the material to enhance student success in ASC 101: Domestic Animal Biology.

Laboratory Manual for Human Physiology provides students with an opportunity to explore physiological processes in a completely hands on series of experiments that make extensive use of ADInstruments PowerLab data collection system. Students work with real biological preparations, including themselves, in both guided and inquiry-based experiments. All lab activities support and include questions that link back to concepts taught in lecture.

This activity is written for upper-level biology courses and aims to acquaint students with the function of transcription factors, especially in determining the fate of cells. Students who complete this activity will explain and illustrate how cells with the same DNA produce different proteins and predict gene activity based on relevant gene regulation factors. Process skill: forming an argument or reaching a conclusion supported with evidence.
POGIL eBooks are delivered through VitalSource – the world’s leading platform for…
This laboratory manual was written with bilingual students in mind. There is Spanish translation for the text and the different experiments that students will be performing in the laboratory, making the instructions easier to understand for our bilingual students.
The laboratory exercises that are going to be performed by the students are designed so that students are going to be able to apply what they learn in their Anatomy and Physiology lectures.
Some of the reagents that are going to be used will be solutions and substances that they encounter in their everyday…

This publication is a microbiology laboratory manual designed for a one-semester, college undergraduate education. The manual is designed to be self-guided so that the students can learn and discover on their own time. All college majors requiring a microbiology laboratory course will benefit from this publication. This manual contains a series of experiments designed to build a student’s knowledge and mastery of microbiological laboratory techniques. It begins with basics of microscopy, aseptic technique, and culture handling, and then advances into diagnostic techniques applicable to…
General Biology Workbook is geared towards both nonmajors and majors in biology, and is designed to provide a comprehensive understanding of the subject matter. Through the use of clear and concise language, engaging visuals, and interactive elements, the book offers a dynamic and accessible approach to learning about biology.
The world we live in is full of fascinating and complex living organisms that have evolved over millions of years. Biology is the science that seeks to understand these organisms and the processes that govern their behavior. Whether you…

This laboratory manual provides students with hands-on experience in fundamental techniques of molecular and cell biology, reinforcing core concepts through practical application. Beginning with essential skills such as solution preparation and pH monitoring, the manual progresses through key experimental methods including spectrophotometry, PCR-based GMO detection, protein isolation and purification, subcellular fractionation, and enzyme kinetics. Each chapter is designed to build technical proficiency and critical thinking, culminating in…
Microbiology is the study of unicellular, multicellular, and/or acellular microorganisms. Ever since Antonie van Leeuwenhoek first set eyes on the microbial world, that world and the knowledge of that world has expanded, in part thanks to other famous names in microbiology. Pasteur, Jenner, Koch, to name a few, have led us into present day microbiology. Current studies link this microbial world to all sorts of diseases that have afflicted humankind and all other life on our planet. While that may seem pessimistic, the microbial world offers a whole host of wonderful and beneficial aspects…

The laboratory manual is intended for non-science majors studying general biology. The biological terminology is kept at a minimum in an attempt to limit the technical jargon. The purpose of this laboratory manual is to expose the students to as many organisms and biological concepts as possible.

Medical Microbiology for Health Professionals presents the reader with new up-to-date information about recent advances in our understanding of health and disease. The knowledge we now have about the role of biofilms in infection helps us understand how infections can become chronic and difficult to treat. Biofilms are part of what we describe as the human microbiome. The microorganisms within our microbiome are revealing themselves as integral to human development, and new information has come to light which may give us more control and allow us to manipulate human health…

Zombies aren’t real. To our knowledge, there are no secret government laboratories working on creating or defeating the zombie menace, but if such laboratories are ever created then sign us up to be the earth’s last, best hope.
Human Zombie Biology provides students the knowledge to gain a greater understanding of the concepts of biology as they apply to zombies. The Centers for Disease Control and Prevention (CDC) has even used zombies to educate the American Public on how to be prepared for any emergency, using the philosophy that…

New Fourth Edition Coming Soon!
We are constantly surrounded by ubiquitous, living organisms too small to be observed by the naked eye. Some of them are beneficial to us. They may serve us as part of our normal microflora competing with and inhibiting the growth of pathogenic microorganisms. Pathogenic and opportunistic microorganisms can cause sickness and diseases in humans, animals and plants. Microbiological techniques enable us to view and study these fascinating creatures.
Within Microbiology Laboratory…

A solid understanding of basic scientific principles is necessary for everyone—regardless of job position or perceived ability to “do science.” Many students will find themselves in a place where they will need to understand some aspect of science. Most will be parents or voters—and presumably all will be consumers. For these reasons alone, all individuals must have some fundamental scientific skills in order to critically analyze situations, scenarios, or products in an objective, balanced way, or else risk damage to one’s self, loved ones, or the environment. Additionally, many will need…

Biology of Women balances the needs of students who are science majors with those of students who do not have a strong scientific background. It is accessible to entry levels students, but offers enough detail and critical thinking opportunities to challenge students who already have some understanding of human anatomy and physiology.
This publication embraces the newer research that identifies significant differences outside of their reproductive systems between men and women, and that these differences can affect everything from physiological functioning to…

The 2nd edition of the Microbiology Lab Manual by Mr. Roger Lighter and Dr. Joshua Burns is designed specifically for the General Microbiology course at the University of Arkansas-Fort Smith. Laboratory exercises have been designed and organized to provide students hands on experience with the tools and techniques of microbiological investigation. Biology majors will learn valuable lab skills that will help prepare them for upper level lab and research activities. At the same time, health science pre-professional students will gain the knowledge and skills…
This lab manual is a survey of experiments and activities that allow students to put their conceptual framework into action while sharpening laboratory skills. These labs have been designed to examine a broad variety of laboratory methods through the use fo aseptic protocols, biochemical tests, selective and differential media, serial dilutions, and techniques one might encounter in the field of microbiology and/or as a health care professional. Post lab questions that follow each lab help reinforce each topic, while leading students to apply their knowledge in new situations.

The goal of this text is to instill a basic curiosity about and respect for microorganisms as students prepare for their future health care professions. The Microbiology Laboratory: An Introduction to Clinical Microbiology Concepts and Techniques promotes the understanding of how microorganisms live and spread, as well as how to deter their presence when needed. This text stresses the importance of constant vigilance in both quality control and infection control practices. Using simulated patient cases, the text introduces identification techniques as well as…

Biology for AP…

This is the lab manual for Biology II, the second semester of a two-semester General Biology course for science majors.
There is much more to biology than memorizing facts in a textbook. The fun part of biology is actually doing it! This laboratory course is designed to help you develop the hands-on skills of biologist using the tools found in a typical, modern biology lab.
Each of the exercises in this manual begins with background to help you understand a core concept of biology. You will then be presented with a question of problem related to that concept. The lab…

This is the lab manual for Biology I, the first semester of a two-semester General Biology course for science majors.
There is so much more to biology than memorizing facts in a textbook. The fun part of biology is actually doing it! This laboratory course is designed to help you develop the hands-on skills of a biologist using the tools found in a typical, modern biology lab.
Each of the exercises in this manual begins with background information to help you understand a core concept of biology. You will then be presented with a question or problem related to that concept…
Techniques of Microorganisms introduces students to methods of culturing microorganisms, staining microorganisms, and identifying bacteria by commonly used techniques. Students will look at the effect of antimicrobial agents on bacteria and be introduced to bacterial genetics, both conjugation and transformation. Each exercise in the laboratory manual is divided into five sections: Introduction, Materials, Procedure, Results, and Questions.

New Edition Now Available!

Discovering the Living Ocean provides a suitable manual in marine biology that is engaging, easy to read, and relevant for nonscience majors in community college as well as for high school students. This publication includes activities that challenge and inspire students to learn more about the Ocean that all of us share and depend on in so many ways. The included activities expose students to some of the multifaceted disciplines that marine biologists must have a working knowledge of: microbiology, zoology, phycology, anatomy, physiology, ecology, and…

Student Lab Manual Supplement for OpenStax Biology for AP Courses (spiral bound)
New Edition Now Available!

New Edition Now Available!

Cell biology continues to be a core course in the biological sciences and living cells continue to thrill biologists, anatomists, ecologists, and medical researchers with new discoveries. With that in mind this lab course was developed so that students not only investigate the molecular biology of cells but also observe and study living cells.
The labs are divided up into four areas: 1) observing cells, 2) cell structure and function, 3) molecular biology and 4) intracellular genetics.
In the sections on observing cells and cell structure and function, living and prepared…

Foundation of Biology Laboratory Manual: Laboratory Manual for General Biology I was created with a threefold purpose:
1. To build a strong foundation for cell biology through laboratory exercises.
2. To build skills in following written instructions and in making careful observations.
3. To provide the laboratory instructor with the flexibility of allowing students to work in teams or individually.
Careful observation and analysis are necessary in every…
































